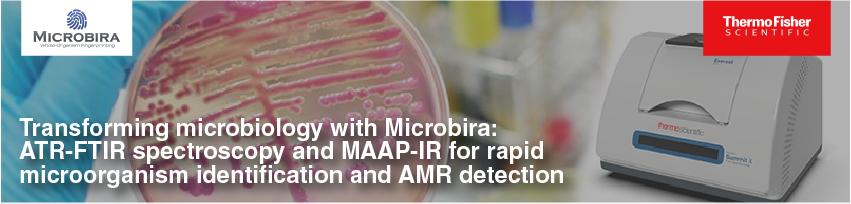

Discover Microbira’s Advanced Analytical Platform (MAAP-IR) software and its applications. MAAP-IR is designed to work with ATR-FTIR spectrometers to deliver rapid and accurate microorganism identification in under 5 minutes from culture plate. Participants will learn how this reagent-free platform achieves high diagnostic performance with minimal sample preparation and turnaround times. We’ll present real-world case studies, clinical validation data, and demonstrate how MAAP-IR can be easily integrated alongside existing identification workflows and culture-based techniques. The combined system of spectroscopy and AI is particularly suitable for smaller labs and for back-up and specialist identifications in larger labs.
Who should attend this event?
This session will be of interest to clinical, veterinary, and public health labs seeking innovative and scalable diagnostic tools for microbial identification and AMR detection.
About the webinar speakers

Marianne Ismail, CEO, Microbira Limited
Marianne Ismail holds a master’s in clinical microbiology and Infectious Diseases from the University of Edinburgh and brings extensive leadership experience in health tech needs and strategy, particularly in LMICs. Over the years she has worked in global businesses and science in small and large international companies. A co-founder of Microbira, she helped shape the company’s direction, built partnerships in the UK and recently in India, and led the successful fundraising for Microbira. Marianne’s work often bridges the gap between scientific ideas and practical, sustainable business models.
Lisa Lam Ph.D., Director of Science and Technology, Microbira Limited
Lisa Lam holds a Ph.D. in Clinical Microbiology from McGill University, where her research focused on biotechnology and diagnostic methods. With a background that includes food sciences, data science, and project management, she has worked across both academic and startup environments. At Microbira, Lisa leads research and development efforts, working on projects that explore new ways to apply FTIR spectroscopy and machine learning in microbiology. She’s also been involved in community driven and socially minded science projects throughout her career.